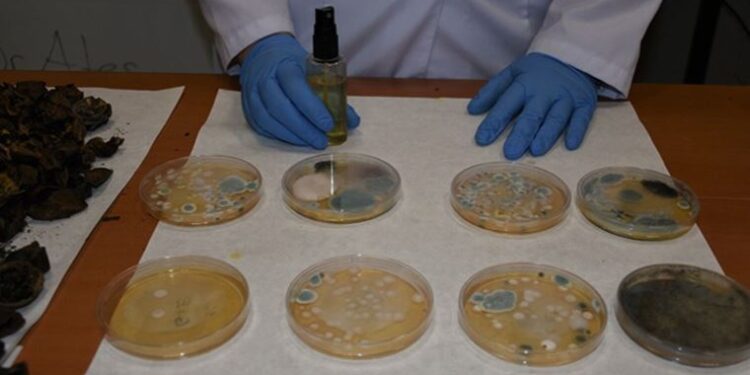

Ceviz kabuklarından dezenfektan ürettiler
Kırşehir’de üniversite öğrencileri pilot uygulamalar kapsamında bölge üreticilerine destek sağlamak amacıyla başlattığı projeyle yeşil ceviz kabuğu atıklarından dezenfektan üretti.
Ziraat Fakültesi Dr. Öğretim Üyesi Mevlüde Alev Ateş ve öğrencileri tarafından yaklaşık bir yıl önce yeşil ceviz kabuğu atıklarından dezenfektan üretilmesi için laboratuvar ortamında çalışma yapıldı.
Çalışma sonucu dezenfektan imal edildi. Üniversite-özel sektör iş birliğiyle yapılacak yatırımla çöpe gidecek tonlarca kabuktan dezenfektan ve sterilizasyon malzemesi üretilerek katma değer oluşturulması hedefleniyor.
TÜRKİYE GENELİNDE 325 BİN TON CEVİZİN KABUĞU ÇÖPE ATILIYOR
Ziraat Fakültesi Dekanı Prof. Dr. Ahmet Kazankaya, Kırşehir'de yılda yaklaşık 5 bin ton, Türkiye genelinde ise 325 bin ton cevizin kabuğunun çöpe atıldığını söyledi.

Kırşehir Ahi Evran Üniversitesinin (KAEÜ) "jeotermal ve tarım" alanında YÖK tarafından pilot seçilmesiyle Ceviz Odaklı Kalkınma Projesi hazırladıklarını belirten Kazankaya, faydalı olduğu değerlendirilen bu ürünün kabuklarının bölge üreticisine katma değer oluşturmasını hedeflediklerini dile getirdi.
Olumlu sonuç elde ettikleri projeyle ilgili yatırımcılara çağrıda bulunan Kazankaya, şöyle konuştu:
"Yaklaşık bir yıl önce bu projenin uygulanabilirliği konusunda çalışmalarımız başladı. Şu anda projemiz sonuçlandı, gayet de güzel sonuçlar ortaya çıktı. Şehrimizde yaklaşık 5 bin ton ceviz kabuğunun katma değeri yüksek ürün haline getirilmesiyle hem bölge üreticileri hem de ülkemiz kazanacak. Bu konuda tesis anlamında yatırım yapıldığı takdirde yaklaşık 5 bin ton ceviz kabuğu çöpe atılacağına üreticilere ek gelir getirecek."
"GÜZEL SONUÇLAR ELDE ETTİK"
Dr. Öğretim Üyesi Mevlüde Ateş de cevizin yeşil kabuğunun içindeki maddelerin geleneksel tıpta yaralanmalarda kan akışını kesici, ateş düşürücü ve yara yüzey sterilizasyonu malzemesi olarak yüzyıllardır kullanıldığını söyledi.
Cevizin çöpe giden yüzde 50'lik kısmı olan yeşil kabuklarını değerlendirerek üretime kazandırmayı hedeflediklerini anlatan Ateş, şunları kaydetti:
"Laboratuvar ortamında yapılan üretimde cevizin yeşil kabukları soyulduktan sonra fırına konularak kurutuluyor. Özel kapta dövüldükten sonra toz haline getirilen yeşil ceviz kabukları, dezenfektan yapımında kullanılmak üzere belirli oranlarda kimyasallarla karıştırılıyor. Farklı çözücüler yardımıyla organik bileşiklerini ortaya çıkartıp bunun antimikrobiyal özelliğini kullanmayı hedefledik. Yaptığımız denemelerde, özellikle pandemi döneminde hayatımıza giren alkollü dezenfektanlara alternatif olarak organik, daha az kimyasal içeren bir dezenfektan üretmiş olduk."
Bir yıllık çalışmada, belirli periyotlarda yaptıkları deneme üretiminde yaklaşık 50 kilogram dezenfekte elde ettikleri çalışmanın daha da geliştirilebileceğini vurgulayan Ateş, "Bu ürünümüzü sadece dezenfektan değil birçok sterilizasyon koşullarında kullanılmak üzere de solüsyonumuzu geliştirdik. Çeşitli denemelere tabii tuttuk ve güzel sonuçlar elde ettik" diye konuştu.